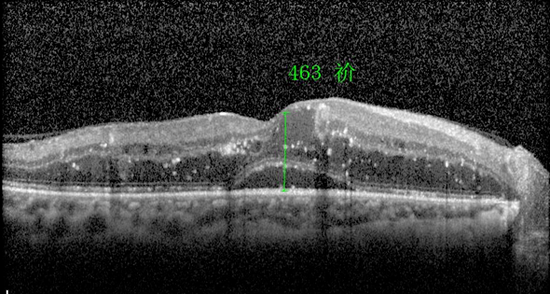

“ 没有一个冬天不可逾越
没有一个春天不会到来 ”
这句话曾在疫情期间温暖了很多人
但四季已经再次更迭
疫情却尚未结束
很多人追寻世间美好的脚步
也因此被阻挡
然而对于一部分人而言
阻挡美好的不止是疫情
还有“生病”的眼睛……

随着人口老龄化进程加快,与年龄相关的一些致盲性眼病的发生率越来越高了。其中,有约40%的致盲性眼病是由新生血管相关眼底疾病导致的。
在以往,不少致盲性眼底病没有有效的治疗方法,而自从抗VEGF药物诞生以来,这部分可能失明的患者视力得以挽救。所以,在眼底病领域,抗VEGF药物应用于多种眼底血管性疾病,是一个里程碑式的巨大进步。

注药治疗前
完成1针后

完成2针后

完成3针后
后疫情时代 共享光明新世界
我院眼底病中心启动
抗VEGF治疗补助计划

补助力度
2022.5.25-2022.12.31期间到眼底病中心完成3针抗VEGF药物注射的患者,在第3针注射后可向病区护士长提出500元补助申请。
补充说明:活动仅限在眼底病中心使用,活动有效期从5月25日到12月31日(即患者必须在这个时间段完成3针注射)
补助流程
1。患者经眼底病中心医生诊断需注射抗VEGF药物治疗
2。第1针注射后,病区护士长将在病历本贴上抗VEGF治疗补助标识,并记录注射日期
3。在有效期内完成第3针注射后先按正常程序进行结算,再带着结算发票回到病区护士站办理补助所需相关材料,经审核后,补助金额将发放到患者或家属的银行卡上。
厦门眼科中心眼底病中心
优秀团队 护佑光明
厦门眼科中心眼底病中心成立于1993年,经过近三十年的不懈努力,已发展成为装备现代、技术精良、梯队合理、在国内外有较强影响力的眼底病诊疗中心,是国家、福建省及厦门市临床重点专科。









